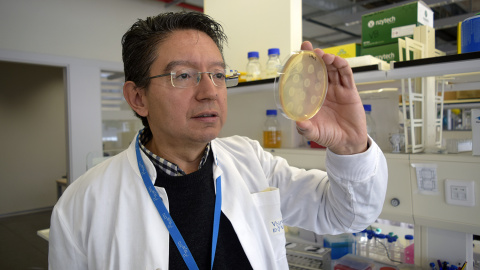
Fotografía Jaramillo

Este artículo se publicó hace 3 años.
Bacterias que juegan al tres en raya y leen morse
La inteligencia artificial no es solo cosa de ordenadores. Es posible modificar bacterias genéticamente para hacerlas capaces de aprender y realizar tareas.

-Actualizado a
La Escherichia coli es una bacteria común en la microbiota de tu intestino. Vive allí feliz, reproduciéndose sin hacerse notar o causando diarreas en ocasiones, a no ser que algún científico quiera aprovechar su versatilidad para hacer experimentos. Si la E. Coli en cuestión cae en manos del valenciano Alfonso Jaramillo, doctor en Física Teórica, investigador del Consejo Superior de Investigaciones Científicas y catedrático emérito de Biología Sintética en la Universidad de Warwick (Reino Unido), está de enhorabuena: su destino ya no será comer las sobras digestivas de cualquier mamífero, sino convertirse en la más puntera forma de biointeligencia artificial. Por lo pronto, ya les ha enseñado a jugar al tres en raya y a una forma simplificada de ajedrez. En la actualidad, está trabajando en entrenarlas a descifrar el código morse.
En su laboratorio en el Instituto de Biología Integrativa de Sistemas (I2SysBio), perteneciente al CSIC y la Universidad de València, las bacterias inteligentes están dispuestas en 27 distintos cultivos, cada uno capaz de hacer una tarea concreta o recibir un tipo específico de señal. Por ejemplo, está el grupo que reconoce la A en código morse (formada por punto y raya), y así con todas las letras del alfabeto. "Cada consorcio de bacterias actúa como un superorganismo en la recepción de la señal", nos explica Jaramillo. Entender el procedimiento no es fácil para novatos. "Primero metemos a las bacterias unos genes que son capaces de reconocer un pulso químico y reaccionar a él poniéndose fluorescentes", señala. Esos pulsos de los que habla son diferentes compuestos químicos, que los científicos de su equipo aplican a los cultivos con una duración de ccinco minutos –equivalente a un punto en código morse– o 15 minutos –equivalente a una raya–.
¿Cómo se entrena a un microbio?
Aunque no es algo que las bacterias genéticamente modificadas sepan hacer desde el principio. Más bien, los investigadores deben enseñarles a reconocer las letras. ¿Y cómo se entrena a una bacteria? El equipo emplea el viejo método de los refuerzos, con premios y castigos: si las bacterias se equivocan –es decir, se encienden cuando no es su turno–, se les aplica antibiótico, que las debilita. Y, cuando aciertan, se aplica otro antibiótico que resulta que no las afecta porque, junto al gen de la fluorescencia, se les ha insertado en el ADN un gen de resistencia a ese antimicrobiano en concreto. "Es una especie de proceso de selección natural. Las que responden acertadamente son también las que tienen la resistencia al antibiótico", apunta Jaramillo.
"El paso dos es hacer que recuerden lo que han percibido, que puedan mostrarlo unas horas después", nos dice el experto. Esa memoria artificial bacteriana se consigue gracias a la cantidad de ADN: "Las bacterias que tienen más copias del gen modificado son las que recuerdan que han percibido ese estímulo". Es lo que hace que, cuando los experimentadores ponen la señal de la letra A (punto y raya), el cultivo especializado en reconocer dicha letra es el que más se ilumina. "Al hacer el experimento muchas veces con el refuerzo positivo y el negativo, la cantidad de ADN se va ajustando al valor que le toca a cada cultivo para poder hacer la diferenciación", añade.
Reñida partida de tres en raya
El mismo método es el que emplearon con éxito para enseñar a la aplicada E. Coli a jugar al tres en raya contra un humano. El experimento comienza con un cultivo para cada posición del tablero, nueve en total. "Les metemos genes que perciben compuestos químicos diferentes. Por ejemplo, si el humano está en el centro, se activa el cultivo de bacterias capaces de reconocer esa posición", nos dice. En la siguiente tirada, son los microbios quienes responden dónde mover: el cultivo que más brilla indica cuál será su nueva posición. "Cuando el humano vuelve a jugar su turno, les ponemos el pulso químico de esa posición –incluyendo su anterior posición–, y así sucesivamente". ¿Y aprenden? Jaramillo nos asegura que sí: "Los cultivos de cada casilla aprenden por separado por ensayo y error. Cuando hacen un movimiento incorrecto, las penalizamos aplicando antibiótico y, con eso, logramos que no se vuelvan a equivocar de esa misma forma".
Alfonso Jaramillo: "Cualquier cosa que se haya hecho con redes neuronales, nosotros la podemos aplicar con bacterias"
Aparte de ser un ejercicio que roza la ciencia ficción, ¿para qué pueden servir este tipo de experimentos? "En un futuro, se usarán sistemas de computación bacteriana que tengan varias comunidades de bacterias comunicándose entre ellas", responde el investigador. Es una idea inspirada en la computación neuromórfica, que imita el funcionamiento de una neurona, en la forma en que guarda una señal percibida y reacciona ante ella. "Cualquier cosa que se haya hecho con redes neuronales, nosotros la podemos aplicar con bacterias", asegura. Lo que hacen en su laboratorio es crear redes neuronales con genes, usando a las bacterias como huéspedes.
Un paso hacia los ordenadores biológicos
En el futuro, ¿habrá ordenadores biológicos? "Ya los tenemos. Hasta el cerebro de un mosquito es capaz de reaccionar en tiempo real si una mano intenta matarlo", observa. Solo queda replicar esa maravillosa capacidad de manera artificial. Las aplicaciones pueden ser tan alucinantes como entrenar a esas bacterias para dosificar la medicación dentro del cuerpo del paciente, en función de su medio interno. Por ejemplo, los microbios podrían soltar determinada dosis de un fármaco en el momento en que la acidez o la temperatura de un órgano cambien.
Por el momento, el equipo de I2SysBio está tan entusiasmado con sus resultados que ya tiene las miras puestas en futuras fases de su investigación. "Mis bacterias son muy lentas. Tardan horas en poder reaccionar. Pero, en un futuro, podremos pasar de usar señales químicas para encender genes –algo que tarda horas o días– a usar señales eléctricas con organismos como los hongos, que ya funcionan en la naturaleza como redes de neuronas bajo tierra", nos dice.
Comentarios de nuestros socias/os
¿Quieres comentar?Para ver los comentarios de nuestros socias y socios, primero tienes que iniciar sesión o registrarte.